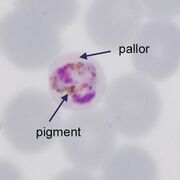
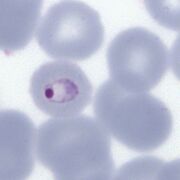

File list
This special page shows all uploaded files.
| Date | Name | Thumbnail | Size | User | Description | Versions |
|---|---|---|---|---|---|---|
| 17:30, 12 November 2024 | LT size 2.jpg (file) |  |
139 KB | Admin | 1 | |
| 17:29, 12 November 2024 | LT size 1.jpg (file) |  |
30 KB | Admin | 1 | |
| 17:28, 12 November 2024 | ET stage 3 title.jpg (file) |  |
49 KB | Admin | 1 | |
| 12:43, 12 November 2024 | LT dots 2.jpg (file) |  |
48 KB | Admin | 2 | |
| 12:43, 12 November 2024 | LT dots 1.jpg (file) |  |
44 KB | Admin | Reverted to version as of 11:37, 12 November 2024 (CET) | 3 |
| 12:24, 12 November 2024 | ET stage 2 title.jpg (file) |  |
47 KB | Admin | 1 | |
| 12:00, 11 November 2024 | ET Hb metabolism-label.jpg (file) | |
148 KB | Admin | 1 | |
| 11:42, 11 November 2024 | ET Hb metabolism.jpg (file) |  |
139 KB | Admin | 1 | |
| 11:36, 11 November 2024 | ET stage 1 title.jpg (file) |  |
46 KB | Admin | 2 | |
| 11:22, 11 November 2024 | ET stage 1c.jpg (file) | |
173 KB | Admin | 1 | |
| 11:10, 11 November 2024 | ET stage 3.jpg (file) |  |
72 KB | Admin | 1 | |
| 10:44, 11 November 2024 | ET stage 2.jpg (file) |  |
48 KB | Admin | 1 | |
| 10:44, 11 November 2024 | ET stage 1.jpg (file) |  |
36 KB | Admin | 1 | |
| 20:05, 7 November 2024 | PKG1.jpg (file) |  |
28 KB | Admin | 1 | |
| 19:57, 7 November 2024 | POG4.jpg (file) |  |
24 KB | Admin | 1 | |
| 12:45, 7 November 2024 | PMG1.jpg (file) |  |
31 KB | Admin | 1 | |
| 18:36, 6 June 2024 | MFcrenation2.jpg (file) |  |
61 KB | Admin | 1 | |
| 18:36, 6 June 2024 | MFcrenation1.jpg (file) |  |
60 KB | Admin | 1 | |
| 12:53, 6 June 2024 | PHincorrect2.jpg (file) |  |
29 KB | Admin | 1 | |
| 12:51, 6 June 2024 | PVLT3ph.jpg (file) |  |
29 KB | Admin | 1 | |
| 09:48, 3 June 2024 | PKET4a.jpg (file) |  |
33 KB | Admin | 1 | |
| 09:47, 3 June 2024 | PKET3a.jpg (file) |  |
33 KB | Admin | 1 | |
| 09:47, 3 June 2024 | PKET2a.jpg (file) |  |
31 KB | Admin | 1 | |
| 09:47, 3 June 2024 | PKET1a.jpg (file) |  |
32 KB | Admin | 1 | |
| 16:50, 1 June 2024 | PKET4.jpg (file) |  |
31 KB | Admin | 1 | |
| 16:49, 1 June 2024 | PKET3.jpg (file) |  |
32 KB | Admin | 1 | |
| 16:49, 1 June 2024 | PKET2.jpg (file) |  |
31 KB | Admin | 1 | |
| 16:49, 1 June 2024 | PKET1.jpg (file) |  |
14 KB | Admin | 1 | |
| 16:37, 1 June 2024 | MET4g.jpg (file) |  |
154 KB | Admin | 1 | |
| 16:37, 1 June 2024 | PMET3g.jpg (file) |  |
27 KB | Admin | 1 | |
| 16:36, 1 June 2024 | MET2g.jpg (file) |  |
173 KB | Admin | 1 | |
| 16:36, 1 June 2024 | MET1g.jpg (file) |  |
173 KB | Admin | 1 | |
| 17:34, 23 May 2024 | POET4g.jpg (file) |  |
48 KB | Admin | 1 | |
| 17:34, 23 May 2024 | POET3g.jpg (file) |  |
40 KB | Admin | 1 | |
| 17:33, 23 May 2024 | POET2g.jpg (file) |  |
49 KB | Admin | 1 | |
| 17:32, 23 May 2024 | POET1g.jpg (file) |  |
40 KB | Admin | 1 | |
| 22:25, 22 May 2024 | PVET4g.jpg (file) |  |
43 KB | Admin | 1 | |
| 22:24, 22 May 2024 | PVET3g.jpg (file) |  |
30 KB | Admin | 1 | |
| 22:24, 22 May 2024 | PVET2g.jpg (file) |  |
33 KB | Admin | 1 | |
| 22:23, 22 May 2024 | PVET1g.jpg (file) |  |
48 KB | Admin | 1 | |
| 21:51, 22 May 2024 | PFET4g.jpg (file) |  |
80 KB | Admin | 1 | |
| 21:49, 22 May 2024 | PFET3g.jpg (file) |  |
76 KB | Admin | 1 | |
| 21:43, 22 May 2024 | PFET2g.jpg (file) |  |
51 KB | Admin | 1 | |
| 21:40, 22 May 2024 | PFET1g.jpg (file) |  |
52 KB | Admin | 1 | |
| 10:09, 21 May 2024 | Mosquito.png (file) |  |
116 KB | Admin | 2 | |
| 22:38, 19 May 2024 | List 2.jpg (file) |  |
67 KB | Admin | 1 | |
| 22:20, 19 May 2024 | Gallery new 2.jpg (file) |  |
48 KB | Admin | 1 | |
| 20:02, 19 May 2024 | Species 2.jpg (file) |  |
63 KB | Admin | 1 | |
| 19:44, 19 May 2024 | RDT new.jpg (file) |  |
84 KB | Admin | 1 | |
| 19:22, 19 May 2024 | Thick 2.jpg (file) |  |
38 KB | Admin | 1 |